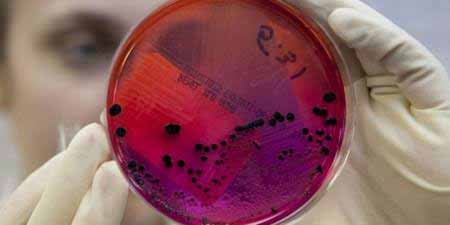
Сибірська виразка : симптоми та профілактика

Таку назву захворювання отримало із-за свого регіону розповсюдження. Під час епідемії перед революцією воно часто зустрічалося в Сибіру. Другий термін, яким позначають хвороба – антракс. Переносниками є домашні тварини. Захворювання виникає після впливу мікроорганізму Bacillus anthracis. Збудники сибірської виразки діють на організм людини руйнівно, виділяючи …
Сибірська виразка : симптоми та профілактика